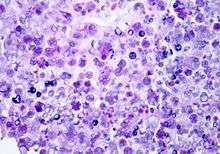

Prototheca wickerhamii
| Prototheca wickerhamii | |
|---|---|
![]() | |
| Scientific classification | |
| Domain: | Eukaryota |
| Kingdom: | Viridiplantae |
| Phylum: | Chlorophyta |
| Class: | Trebouxiophyceae |
| Order: | Chlorellales |
| Family: | Chlorellaceae |
| Genus: | Prototheca |
| Species: | P. wickerhamii |
| Binomial name | |
| Prototheca wickerhamii | |
Prototheca wickerhamii is a ubiquitous green alga that does not have chlorophyll. It is widely present in the environment and is a rare cause of infection in humans (protothecosis) and most commonly presents as nodules of the skin.[1] Most cases reported have a suppressed immune system (from drugs or disease). Infection usually results by direct traumatic inoculation.[2]
Identification
Diagnosis can be made through culture of infected fluid in Sabouraud dextrose agar or by visualization of sporangia containing sporangiospores on tissue biopsy (using hematoxylin/eosin, GMS, or PAS histochemical stains). The organism incites a chronic granulomatous inflammation with infiltrate of histiocytes, lymphocytes, giant cells and occasional eosinophils. The organism has thick wall, internal septations, measures 3-11 µm in diameter. The sporangia have very small wedge-shaped endospores arranged radially and moulded (morula-like form).[2]
Differential diagnosis: Protothecal sporangia may be confused with Coccidioides immitis, which are much larger
Antimicrobial therapy
Treatment is not standardized. Amphotericin B, itraconazole, posaconazole and voriconazole have all been tried.[1]